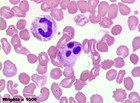
Picture for song 'Bleeding Alcohol' by artist 'kevinduprey'

kevinduprey
acoustic guitar, piano
13
songs
1.1K
plays

Over My Head / Cable Car Over My Head / Cable Car
My version of the Fray song. I wish I had somewhat of a vocal range.

goodbye goodbye
Bleeding Alcohol Bleeding Alcohol
i wrote this one sunday when i didn't feel like studying. here are some red blood cells and neutrophils for your viewing pleasure.

sounds made by a guitar sounds made by a guitar
these are sounds made by a guitar! i don't know who that is in the picture, but i like it

let it fall let it fall
I wrote this song after college graduation. It's about the seasons changing...and things falling down. Interpret as you wish...
Show all (13)
Your musical influences
everything...just click on musicWhat equipment do you use?
acoustic guitar, piano, tin can, garbage can, brush, whatever i can find...Contact
Sorry, this artist currently doesn't accept email messages.
Promoted
Not related to artist